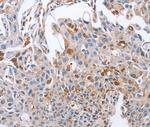
NRG4 Antibody in Immunohistochemistry (Paraffin) (IHC (P))

Search
Invitrogen
NRG4 Polyclonal Antibody
{{$productOrderCtrl.translations['antibody.pdp.commerceCard.promotion.promotions']}}
{{$productOrderCtrl.translations['antibody.pdp.commerceCard.promotion.viewpromo']}}
{{$productOrderCtrl.translations['antibody.pdp.commerceCard.promotion.promocode']}}: {{promo.promoCode}} {{promo.promoTitle}} {{promo.promoDescription}}. {{$productOrderCtrl.translations['antibody.pdp.commerceCard.promotion.learnmore']}}

Please note: We are reviewing Western blot images included in the antibody testing data in our catalog, including those provided by third parties. Unless expressly labeled or annotated as “raw-unedited”, Western blot images included in the antibody testing data in our catalog may have been edited, optimized or otherwise adjusted for presentation.
产品信息
PA5-50341
种属反应
宿主/亚型
分类
类型
抗原
偶联物
形式
浓度
规格
纯化类型
保存液
内含物
保存条件
运输条件
RRID
产品详细信息
The antibody detects endogenous levels of total NRG4 protein.
靶标信息
Neuregulin 4 (NRG4) is a member of the Neuregulin family serving as a ligand for the epidermal growth factor receptor (EGFR) family, specifically interacting with ERBB4. This gene is primarily expressed in brown adipose tissue and liver, where it plays a pivotal role in metabolic regulation. NRG4 acts as a critical signaling molecule in adipose tissue, promoting systemic glucose homeostasis and energy expenditure while inhibiting hepatic lipogenesis, thereby contributing to protection against diet-induced obesity and insulin resistance. Moreover, NRG4 expression is inversely correlated with adiposity and positively correlated with insulin sensitivity, suggesting its potential role in metabolic homeostasis. Studies reveal that NRG4's interaction with ERBB4 stimulates specific cellular pathways, which can impact hepatic gluconeogenesis, underscoring its importance in glucose metabolism. Additionally, NRG4 has been linked to breast cancer progression, where it contributes to tumor cell survival through signaling pathways involving receptor tyrosine kinases. Due to its significant involvement in metabolic pathways and cancer biology, NRG4 is considered a promising target for therapeutic intervention in metabolic disorders and certain cancers.
仅用于科研。不用于诊断过程。未经明确授权不得转售。




